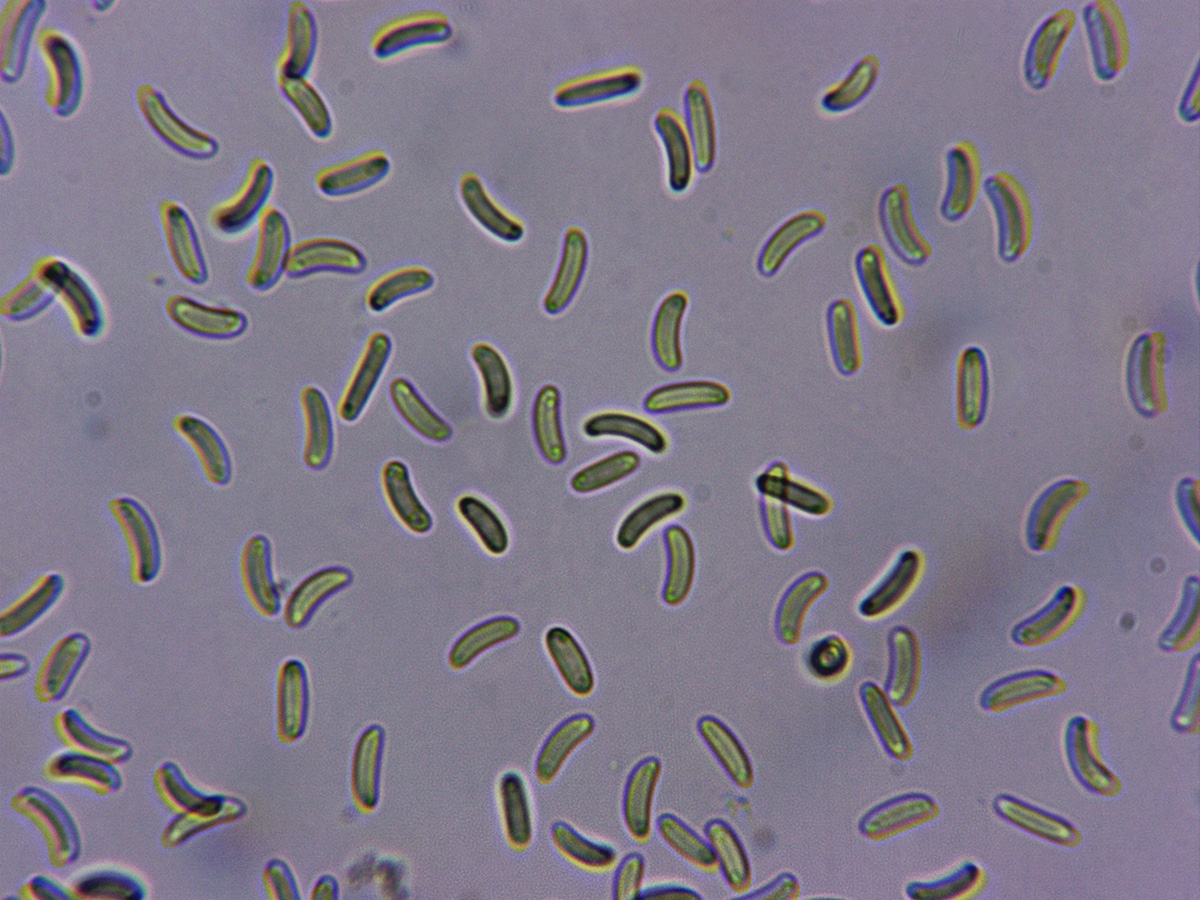

- Foro
- Foros sobre Micología de fungipedia
- Microscopía
- Eutypa flavovirens (Pers.) Tul. & C. Tul. (1863) y alguna cosilla mas.
 Eutypa flavovirens (Pers.) Tul. & C. Tul. (1863) y alguna cosilla mas.
Eutypa flavovirens (Pers.) Tul. & C. Tul. (1863) y alguna cosilla mas.
- Josep Torres
-
 Autor del tema
Autor del tema
- Fuera de línea
- Moderador
-

Menos
Más
- Mensajes: 8745
- Gracias recibidas: 8379
7 años 18 horas antes #102032
por Josep Torres
Hola a tod@s.
Para empezar un "cromo nuevo", del pasado domingo, sobre tronco de planifolio indeterminado en cauce fluvial.
Eutypa flavovirens
Pequeños cuerpos fructíferos a modo de verrugas reventando la corteza del tronco huésped.
El interior de los mismos a 20 aumentos, el tejido del estroma de un característico color amarillo verdoso intenso.
Y a 40 aumentos:
Y la sección del mismo:
La microscopía:
Ascas a 400 aumentos.
Ascas a 1000 aumentos en Rojo Congo diluido.
Ascas en agua destilada a 1000 aumentos.
Ascas octospóricas.
Esporas obtenidas de manara forzada en Rojo Congo diluido.
Esporas obtenidas por esporulación natural en agua destilada.
Las medidas de:
(6) 6.8 - 7.9 (8.3) × (1.8) 2 - 2.4 (2.8) µm
Q = (2.4) 2.9 - 3.7 (4.4) ; N = 40
Me = 7.4 × 2.2 µm ; Qe = 3.3
Totalmente acordes con la bibliografía de la misma.
Seguimos con mas cosas de estos últimos días:
Aunque muy tímidamente ya empiezan a aparecer, Cyclocybe cylindracea
Sobre una Xylariaceae, Calcarisporium arbuscula
Una Ceriporia por partida doble, aunque con un aspecto bastante distinto una de otra, Ceriporia purpurea
Con sistema hifal monomítico sin fíbulas, ausencia de cistidios y esporas en este estudio con unas medidas de:
(5.6) 5.8 - 6.7 (7.4) × (1.9) 2.1 - 2.6 (2.8) µm
Q = (2.3) 2.4 - 3 (3.2) ; N = 40
Me = 6.3 × 2.4 µm ; Qe = 2.7
Otra Ceriporia, esta bastante desconocida, sobre madera de Populus que se confunde habitualmente con la Ceriporia reticulata, la Ceriporia alachuana
Con unas medidas esporales muy por debajo de la Ceriporia reticulata (7;9,5 x 2;3,5), en este caso de:
(4.1) 4.5 - 5.1 (5.3) × (1.9) 2.1 - 2.5 (2.7) µm
Q = (1.9) 1.94 - 2.2 (2.5) ; N = 50
Me = 4.9 × 2.3 µm ; Qe = 2.1
Muy concordantes con la bibliografía de la misma (4-5 x 2-2.5 μm.)
Una ya un poco deteriorada, Daedaleopsis confragosa var. tricolor = Daedaleopsis tricolor
Un Mixomiceto que hasta ahora se me había resistido y ahora lo encuentro cada semana, Hemitrichia clavata
En una nueva medición de sus esporas el resultado de:
(8.5) 8.7 - 9.69 (9.7) × (7.8) 8 - 9.4 (9.5) µm
Q = 1 - 1.1 (1.2) ; N = 20
Me = 9.2 × 8.6 µm ; Qe = 1.1
Otro clásico, Hymenochaete rubignosa
Una Lenzites de considerable tamaño y sombrero glabro, Lenzites warnieri
Otro Mixomiceto, este por su peculiar forma de abrirse (en forma de flor) parece claro, Physarum nutans
Y para terminar una Trametes que si bien ya había estudiado en un par de ocasiones, nunca había podido obtener una imágen de sus esporas, en esta caso con bastante paciencia, las he obtenido en grandes cantidades y por esporulación natural, Trametes versicolor
Las medidas de estas sobre 50 esporas de:
(4.8) 5.5 - 7.4 (8.1) × (2.1) 2.2 - 2.8 (3.2) µm
Q = (2) 2.2 - 2.9 (3) ; N = 50
Me = 6.4 × 2.5 µm ; Qe = 2.6
Saludos a tod@s.
Para empezar un "cromo nuevo", del pasado domingo, sobre tronco de planifolio indeterminado en cauce fluvial.
Eutypa flavovirens
Pequeños cuerpos fructíferos a modo de verrugas reventando la corteza del tronco huésped.
El interior de los mismos a 20 aumentos, el tejido del estroma de un característico color amarillo verdoso intenso.
Y a 40 aumentos:
Y la sección del mismo:
La microscopía:
Ascas a 400 aumentos.
Ascas a 1000 aumentos en Rojo Congo diluido.
Ascas en agua destilada a 1000 aumentos.
Ascas octospóricas.
Esporas obtenidas de manara forzada en Rojo Congo diluido.
Esporas obtenidas por esporulación natural en agua destilada.
Las medidas de:
(6) 6.8 - 7.9 (8.3) × (1.8) 2 - 2.4 (2.8) µm
Q = (2.4) 2.9 - 3.7 (4.4) ; N = 40
Me = 7.4 × 2.2 µm ; Qe = 3.3
Totalmente acordes con la bibliografía de la misma.
Seguimos con mas cosas de estos últimos días:
Aunque muy tímidamente ya empiezan a aparecer, Cyclocybe cylindracea
Sobre una Xylariaceae, Calcarisporium arbuscula
Una Ceriporia por partida doble, aunque con un aspecto bastante distinto una de otra, Ceriporia purpurea
Con sistema hifal monomítico sin fíbulas, ausencia de cistidios y esporas en este estudio con unas medidas de:
(5.6) 5.8 - 6.7 (7.4) × (1.9) 2.1 - 2.6 (2.8) µm
Q = (2.3) 2.4 - 3 (3.2) ; N = 40
Me = 6.3 × 2.4 µm ; Qe = 2.7
Otra Ceriporia, esta bastante desconocida, sobre madera de Populus que se confunde habitualmente con la Ceriporia reticulata, la Ceriporia alachuana
Con unas medidas esporales muy por debajo de la Ceriporia reticulata (7;9,5 x 2;3,5), en este caso de:
(4.1) 4.5 - 5.1 (5.3) × (1.9) 2.1 - 2.5 (2.7) µm
Q = (1.9) 1.94 - 2.2 (2.5) ; N = 50
Me = 4.9 × 2.3 µm ; Qe = 2.1
Muy concordantes con la bibliografía de la misma (4-5 x 2-2.5 μm.)
Una ya un poco deteriorada, Daedaleopsis confragosa var. tricolor = Daedaleopsis tricolor
Un Mixomiceto que hasta ahora se me había resistido y ahora lo encuentro cada semana, Hemitrichia clavata
En una nueva medición de sus esporas el resultado de:
(8.5) 8.7 - 9.69 (9.7) × (7.8) 8 - 9.4 (9.5) µm
Q = 1 - 1.1 (1.2) ; N = 20
Me = 9.2 × 8.6 µm ; Qe = 1.1
Otro clásico, Hymenochaete rubignosa
Una Lenzites de considerable tamaño y sombrero glabro, Lenzites warnieri
Otro Mixomiceto, este por su peculiar forma de abrirse (en forma de flor) parece claro, Physarum nutans
Y para terminar una Trametes que si bien ya había estudiado en un par de ocasiones, nunca había podido obtener una imágen de sus esporas, en esta caso con bastante paciencia, las he obtenido en grandes cantidades y por esporulación natural, Trametes versicolor
Las medidas de estas sobre 50 esporas de:
(4.8) 5.5 - 7.4 (8.1) × (2.1) 2.2 - 2.8 (3.2) µm
Q = (2) 2.2 - 2.9 (3) ; N = 50
Me = 6.4 × 2.5 µm ; Qe = 2.6
Saludos a tod@s.
El siguiente usuario dijo gracias: Juan Andrés Román, Jon Joseba Arnedo
Por favor, Identificarse para unirse a la conversación.
- Jon Joseba Arnedo
-

- Fuera de línea
- Moderador
-

Menos
Más
- Mensajes: 3702
- Gracias recibidas: 3555
6 años 11 meses antes #102034
por Jon Joseba Arnedo
Respuesta de Jon Joseba Arnedo sobre el tema Eutypa flavovirens (Pers.) Tul. & C. Tul. (1863) y alguna cosilla mas.
Muy bonita esa Eutypa, Josep. No tenía ni idea de su existencia
El siguiente usuario dijo gracias: Josep Torres
Por favor, Identificarse para unirse a la conversación.
- Juan Andrés Román
-

- Fuera de línea
- Spammer
-

Menos
Más
- Mensajes: 2558
- Gracias recibidas: 2756
6 años 11 meses antes #102058
por Juan Andrés Román
Respuesta de Juan Andrés Román sobre el tema Eutypa flavovirens (Pers.) Tul. & C. Tul. (1863) y alguna cosilla mas.
Buen post Josep........ en especial me ha gustado la Eutypa flavovirens, con un buen corte yo le sacaría chispas a esos amarillos 
Un abrazo.
Un abrazo.
El siguiente usuario dijo gracias: Josep Torres
Por favor, Identificarse para unirse a la conversación.
- Foro
- Foros sobre Micología de fungipedia
- Microscopía
- Eutypa flavovirens (Pers.) Tul. & C. Tul. (1863) y alguna cosilla mas.
Tiempo de carga de la página: 0.200 segundos

Foro de micología